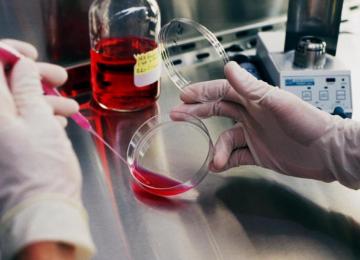

As an interdisciplinary subject, biotechnology provides the ground for commercialization to which professionals and graduates of all disciplines can contribute to, Mehr news agency reported this…
Sci & Tech
Read the latest news about Iran's technology industries, from startups, mobile networks, innovative companies and e-commerce.
- Sci-&-Tech
The assistant director-general of the United Nations Educational, Scientific and Cultural Organization (UNESCO) said earlier this week that she has always admired the advances Iran has made in…
Sci-&-TechSouth Korean flat panel maker LG Display Co. showcased on Tuesday a detachable organic light-emitting diode (OLED) panel that sticks to the wall, renewing its pledge to focus on the high-end…
Sci-&-TechLine, the Japanese messaging app with 205 million active users, is continuing its push into entertainment services after it began testing a standalone $2 per month music streaming app,…
Sci-&-TechLG, South Korea's second largest electronics manufacturer, has announced it will tie up with Arman Hamrah Aryan Company in Tehran for distribution of their electronic devices inside the country,…
Sci-&-TechIranian researchers have unveiled the first locally-made anti-explosion electromotor with a 230 KW capacity, ISNA reported on Monday. At the event another group of researchers also inaugurated its…
Sci-&-TechNearly six months have passed since all three mobile phone operators started offering 3G services across the nation. The parliament's communication regulation committee, however, has banned its…
Sci-&-TechApple Inc. was handed a mixed ruling by a US appeals court in the latest twist in a blockbuster intellectual property battle with Samsung, as a prior patent infringement verdict was upheld but a…
Sci-&-TechSony has announced a new product that will put a Bluetooth speaker into your room in a way that you might not even notice the speaker is there.
The product has been unveiled in Japan…
Sci-&-TechIranian researchers have conducted a study and developed a new set of products for sterilization of bedsores, using a new form of nanotechnology.
Sci-&-TechSearch, education, sport and writing remain popular online activities in Iran; however, new trends like online retail are beginning to push towards the top. Media hosting websites are also popular…
Sci-&-TechA new website has gone online allowing people to create a mobile application for all of the three major smartphone platforms, Webna reports.
The first-of-a-kind application, developed…
Sci-&-TechA comprehensive project focused on the fortification and expansion of communication infrastructure networks, named Tavana, has been launched in Iran, Mehr news agency reported on Monday. …
Sci-&-TechWaiting for mobile OS updates to reach your shiny handset is one of the most frustrating (first world) problems there is, so it's encouraging to hear that Microsoft is planning to take matters out…
Sci-&-TechA Russian Proton-M rocket carrying a Mexican satellite malfunctioned and crashed in Siberia soon after launch on Saturday, the latest in a series of mishaps for Russia’s space industry, Reuters…
Sci-&-TechOne of Iran's largest startup events is returning the Iranian capital this month with a jam packed agenda according to the organizers. The event run in association with IR Startups, aims to be the…
Sci-&-TechThe internet will not need to be rationed in the future because of a ‘data capacity crunch’, according to a leading scientist from British telecoms giant BT, Press Association reported on Tuesday…
Sci-&-TechResearchers in America have discovered how people can decipher male from female, Medical Express reported.
Sci-&-TechGoogle has announced it is banning user edits to its Google Maps after admitting it can’t stop people from abusing the system. However the policy does not apply to Iran.
In April, the firm…
Sci-&-TechThe first conference on "Smartphone Use and Lifestyles" will be held on June 10-11, IRNA reported on Monday.
Debates will include the socio-cultural effects of smartphone usage and national…
Sci-&-TechCalling non-urgent three digit service numbers will no longer be free of charge, ISNA reported on Sunday. Following the approval of the parliament, phone bills issued by the…
Sci-&-TechAsus has launched its ZenFone 2 smartphone - which was released in its home country of Taiwan back in March this year - in Malaysia, GSM Arena reported on Sunday.
Sci-&-TechNearly 10 trillion rials ($300 million at market exchange rate) have been allocated to “commercializing technology”, said a presidential deputy to IRNA.
To support inventors and promote…
Sci-&-TechIran's relatively new e-commerce industry is gradually gaining traction as more e-retailers come online. In no more than two years, Hamechiiz, an online store specializing in apparel and design,…
Sci-&-TechThe source of mysterious signals that left astronomers at Australia's most famous radio telescope scratching their heads for 17 years has finally been found - and it's a …
Sci-&-Tech